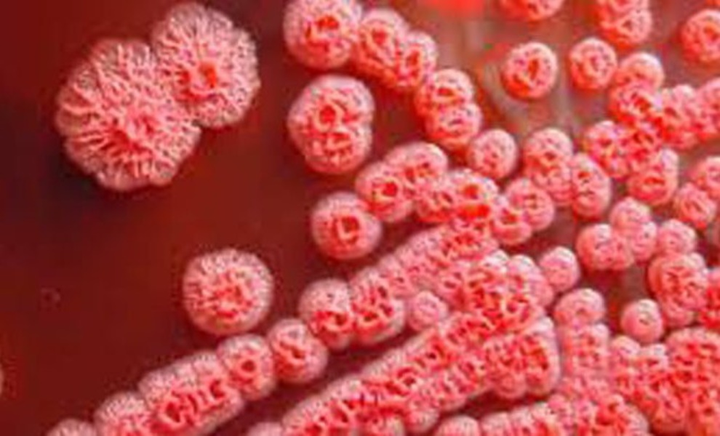
Xét nghiệm COVID-19 lại phát hiện mắc vi khuẩn 'ăn thịt người' - 2

TS - BS Hoàng Công Tình, Trưởng Khoa Hồi sức tích cực - Chống độc, Bệnh viện Đa khoa tỉnh Hòa Bình cho biết, bệnh nhân là nam, 45 tuổi, làm việc trong trại nuôi lợn ở khu công nghiệp thuộc tỉnh Bắc Giang, thường ngày cho lợn ăn, tắm rửa cho lợn và vệ sinh chuồng trại. Khi đang làm việc ở trại nuôi lợn, bệnh nhân xuất hiện sốt cao liên tục 3 ngày, sau đó khó thở tăng dần nên phải về quê (Tân Lạc, Hoà Bình) để khám bệnh.
Khi nhập y tế cơ sở, bệnh nhân có tình trạng sốt cao liên tục, khó thở và tình trạng viêm phổi nặng. Với yếu tố dịch tễ không rõ ràng như vậy, y tế cơ sở đã chủ động cách ly bệnh nhân để điều trị và phối hợp với Trung tâm kiểm soát dịch bệnh (CDC) của tỉnh, làm xét nghiệm (RT-PCR) sàng lọc COVID-19.
Khi chưa có kết quả RT-PCR, bệnh nhân suy hô hấp nặng kèm theo tình trạng sốc nhiễm khuẩn nên được hội chẩn chuyển đến BVĐK tỉnh Hòa Bình.

Bác sĩ thăm khám cho bệnh nhân mắc Whitmore tại BV Đa khoa tỉnh Hòa Bình. (Ảnh: TS - BS Hoàng Công Tình)
Bệnh nhân trong tình trạng lơ mơ nên không khai thác được yếu tố dịch tễ. Qua người nhà cũng chỉ biết là bệnh nhân làm công nhân ở Trại nuôi lợn trong khu công nghiệp, bị sốt cao 3 ngày thì về quê chữa bệnh.
Với tình trạng viêm phổi nặng, cùng với yếu tố dịch tễ không rõ ràng, Bệnh viện đa khoa tỉnh Hoà Bình đã chủ động phòng ngừa COVID-19 bằng cách bố trí khu riêng biệt để điều trị và chăm sóc bệnh nhân, đồng thời phối hợp với CDC của tỉnh để có kết quả RT-PCR trong thời gian sớm nhất.
Bên cạnh đó, bệnh nhân cũng được chỉ định nuôi cấy máu, cấy đờm để tìm nguyên nhân do vi khuẩn hoăc vi nấm. Được sử dụng kháng sinh phổ rộng, phối hợp kháng sinh. Hỗ trợ các tạng suy bằng thở máy, lọc máu liên tục và thay huyết tương.Ngay trong đêm, CDC thông báo kết quả RT-PCR âm tính. Ngày hôm sau, các bác sỹ tiếp tục hội chẩn với CDC để xét nghiệm RT-PCR lần 2 và ngay trong đêm cũng cho kết quả âm tính.
"Yên tâm loại trừ COVID-19, chúng tôi tập trung tìm nguyên nhân gây viêm phổi-sốc nhiễm khuẩn-suy đa tạng. Hai hôm sau, kết quả cấy máu phân lập được vi khuẩn dậy bệnh Whitmore (melioidosis)-cặn bệnh vẫn được đồn đoán là "vi khuẩn ăn thịt người", TS - BS Hoàng Công Tình cho biết.
(Ảnh minh họa)
Do được điều trị tích cực, hiện bệnh nhân qua cơn nguy kịch. Bệnh nhân bỏ được máy thở, bỏ được thuốc vận mạch và dừng lọc máu liên tục mà vẫn đảm bảo các chỉ số sinh tồn.







Bình luận